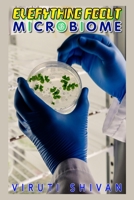
Everything About Microbiomes: Understanding Your Microbiome and Its Impact on Your Health (Everything About Series B0CCZWRZLS Book Cover

- Clinical Documentation Specialist - The Comprehensive Guide
- Medical Biller - The Comprehensive Guide: Mastering the Art of Healthcare Billing and Coding (Medical Allied Health Comprehensive Guides: Your Path to Proficiency)
- Community Health Worker - The Comprehensive Guide
- MEDICAL REVENUE CYCLE MANAGEMENT - One Book To Make You Genius
- Clinical Trial Manager - The Comprehensive Guide